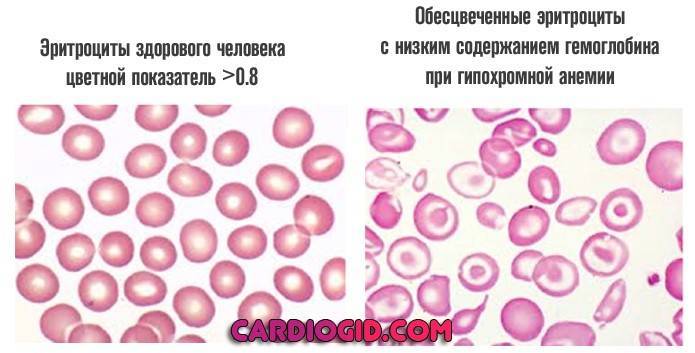
image
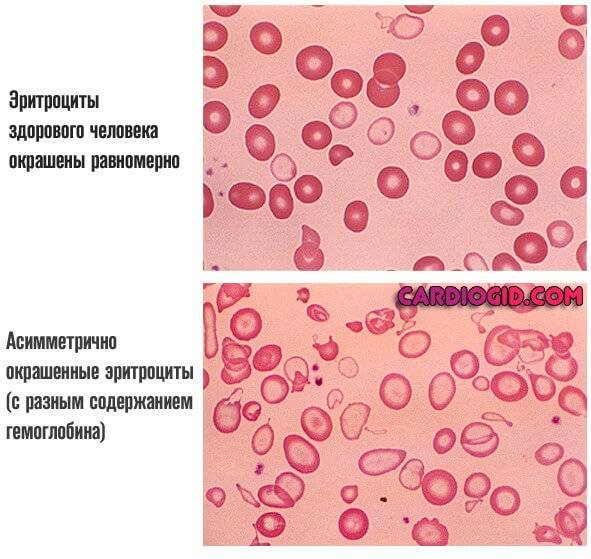
image

Анемии являются одними из самых распространённых заболеваний системы кроветворения. В их число входит и гипохромная анемия. Под этим названием объединяют сразу несколько патологических состояний, при которых отмечается снижение гемоглобина, из-за чего цветовой показатель крови опускается ниже 0,8. Для лечения важно пройти полное обследование, которое позволит определить причину появления нарушения.
Что представляет собой заболевание
Гипохромная анемия включает несколько заболеваний, при которых отмечается нехватка гемоглобина, и в том числе талассемию и железодефицитную анемию. Снижение уровня гемоглобина приводит к нарушению снабжения тканей кислородом, так как именно это вещество отвечает за данный процесс. Такое состояние часто называют малокровием. Форма эритроцитов при данном нарушении изменяется на кольцеобразную. Страдают от малокровия в равной степени взрослые и дети.
Гемоглобин является железосодержащим белком, который присутствует внутри эритроцитов. Когда его количество снижается, нарушается работа красных кровяных телец. В результате ткани и органы начинают испытывать кислородное голодание, отрицательно сказывающееся на их работе. Без лечения состояние усугубляется, начинают развиваться осложнения, ухудшающие прогноз для больного.
Причины гипохромной анемии
Причинами развития патологического состояния могут быть различные факторы. В зависимости от того, какая из разновидностей нарушения имеет место, определяется и провоцирующий её фактор. Основные причины гипохромной анемии следующие:
- кровотечение, при котором развивается потеря значительного объёма крови. Они могут быть патологическими или естественными (при особенно сильной менструации у женщин);
- неправильное питание, при котором организм не получает достаточного количества витаминов и минералов;
- длительные скрытые внутренние кровотечения, вызывающие не объёмную, но постоянную кровопотерю;
- инфекционные патологии, имеющие длительное или хроническое течение;
- интоксикация ядами, химическими соединениями и свинцом;
- период беременности, если женщина недостаточно внимательно следит за своим состоянием;
- глистные поражения;
- аутоиммунные патологии.
У детей выделяют и ещё несколько причин появления анемии в раннем возрасте. К ним относятся:
- резус-конфликт, который возникает между кровью плода и матери;
- внутриутробное инфицирование;
- родовые травмы;
- неправильное питание матери при беременности.
Также у грудных детей анемия часто развивается в том случае, если они находятся на искусственном кормлении, а смесь, которую они получают, оказывается недостаточно качественной.
Разновидности
Выделяют четыре основные разновидности гипохромной анемии.
- Микроцетарная железодефицитная. Самая распространённая, возникающая из-за кровопотери и неправильного питания. В группе риска находятся женщины детородного возраста и дети .
- Железонасыщенная. При патологии в крови концентрация железа в норме, но так как оно оказывается неспособным всасываться, то гемоглобин начинает понижаться. Больше всего от нарушения страдают пожилые, злоупотребляющие алкоголем, а также лица, которые перенесли тяжёлое отравление химическими веществами.
- Железоперераспределительная. Состояние характеризуется повышением количества железа в крови на фоне раннего разрушения эритроцитов. Такое явление характерно для туберкулёза и гнойных процессов в организме.
- Смешанного типа. Патология формируется по причине нехватки в организме не только железа, а и витамина В12. При таком нарушении возникает значительное снижение иммунитета и развитие отёков, которые локализованы в области рук.
Какая форма болезни имеет место, определяется врачом после обследования пациента и получения всех данных анализов крови.
Симптомы и признаки гипохромной анемии
Симптомы нарушения, в зависимости от степени нехватки гемоглобина, проявляются более или менее сильно. Чем она выше, тем более выраженной будет симптоматика.
| Степень анемии | Симптомы |
|---|---|
| Лёгкая | Чаще течение бессимптомное. В редких случаях отмечается лёгкая слабость и несколько повышенная утомляемость |
| Средняя | Головокружения, одышка, бледность кожи и слизистых, повышенный пульс |
| Тяжёлая | Эпизодическое онемение рук и ног, ломкость ногтей, выпадение волос, обмороки, сильная слабость, потеря работоспособности, изменение вкуса, сонливость, непроходящая усталость, постоянное плохое самочувствие |
Лечение анемии является обязательным, так как без него при тяжёлой форме патологии высок риск летального исхода. Продолжать вести нормальную жизнь при средней степени снижения гемоглобина оказывается невозможно.
Особенности проявления у детей
У детей часто нарушение определяется только по анализу крови при плановой диспансеризации или при наличии показаний для исследования крови. Кроме того, о нарушении состава крови могут свидетельствовать такие проявления:
- бледность,
- снижение аппетита,
- ухудшение сна,
- вялость,
- частые простудные заболевания,
- образование трещинок в уголках рта,
- некоторая задержка в физическом и умственном развитии.
Без лечения анемия у ребёнка приводит к серьёзным отклонениям.
Диагностика
Для диагностики снижения уровня гемоглобина в крови проводится анализ крови. Результаты его расшифровывают с учётом факторов, которые влияют на пациента, и его индивидуальных особенностей. Также проводится сбор анамнеза заболевания и жалоб больного. Дополнительно при выявлении снижения уровня железа в крови назначаются УЗИ почек, рентген лёгких, в тяжёлых случаях пункция костного мозга, прохождение женщинами гинеколога.
Лечение гипохромной анемии
Лечение зависит от причины появления заболевания. Если малокровие возникает на фоне основной болезни, то в первую очередь необходимо устранить её. Когда же нарушение спровоцировано неправильным питанием, то достаточно бывает изменения диеты. При терапии также могут назначаться препараты железа, витамин В12 и фолиевая кислота. Форма выпуска средства, которое показано к применению, подбирается индивидуально в зависимости от особенностей пациента и степени анемии.
Прогноз и возможные осложнения
При своевременном лечении прогноз благоприятный. Отсутствие терапии приводит к тому, что начинают развиваться осложнения, основные из которых следующие:
- падение иммунитета,
- увеличение печени,
- нарушения в работе нервной системы,
- отставание в развитии у детей.
При появлении негативных последствий состояния прогноз ухудшается.
Профилактика заболевания
Основные профилактические меры против заболевания: правильное питание, регулярная плановая сдача крови для выявления нарушения в самом начале и прохождение диспансеризации.
Причины
Причины гипохромной анемии могут быть физиологическими. Так, она наблюдается у подростков в период гормональных изменений, у беременных женщин в момент формирования плацентарного круга кровообращения. Это состояние также может наблюдаться при нарушении питания – у приверженцев строгих диет, вегетарианцев, а также младенцев, находящихся на искусственном вскармливании.
Чаще всего гипохромия сопровождает какое-либо заболевание. У новорожденных и недоношенных детей она возникает из-за резус-конфликта, внутриутробного инфицирования вирусами герпеса или краснухи, неправильного питания матери во время вынашивания, а также при родовой травме.
У взрослых причиной гипохромной анемии может быть обильное кровотечение, которое, в свою очередь, вызывают бытовые травмы и ранения, послеоперационные травмы и даже сильная менструация у женщин. Нередко гипохромия развивается при внутренних кровоизлияниях, когда кровопотери незначительные, но частые. Это может наблюдаться при кровоточивости десен, геморрое, заболеваниях ЖКТ, опухолевых процессах.
Гипохромия сопровождает хронические инфекционные болезни, при которых нарушаются процессы усвоения и перераспределения железа, – туберкулез, энтероколит, гепатит. У пожилых людей анемия может возникнуть при болезни печени и почек.
Гипохромная анемия развивается при отравлении химическими элементами, токсинами глистов. И, конечно, это явление можно наблюдать при заболеваниях крови и аутоиммунных патологиях, приводящих к гибели эритроцитов и снижению гемоглобина.
Классификация
Гипохромная анемия имеет несколько механизмов развития. В соответствии с ними она подразделяется на железодефицитную или микроцитарную, сидероахрестическую или железонасыщенную и железораспределительную.
Железодефицитная анемия – самый распространенный вид гипохромии. Она связана с дефицитом железа в организме. Это состояние может развиться вследствие кровотечения или же отсутствия микроэлемента в пище. Такое состояние иногда наблюдается после хирургических операций на органах желудочно-кишечного тракта или при постоянной диарее. Дефицит может возникнуть при повышенной потребности в железе, что наблюдается, к примеру, при беременности и лактации. Наконец, железо может просто не поступать в пищу, если человек не употребляет мяса и продуктов, которые восполняют потребности в этом микроэлементе.
Сидероахрестическая анемия по-другому называется железонасыщенной. В этом случае микроэлемент поступает с пищей в достаточном количестве, но организм не может его усвоить и использовать в производстве гемоглобина. Эта ситуация наблюдается у людей преклонного возраста, а также при отравлении токсинами, например, у работников предприятий химической промышленности или у людей, пострадавших от выброса в атмосферу химических загрязнителей. Такое состояние может наступить и при длительном лечении некоторыми медикаментами.
Железораспределительная анемия – состояние, при котором железо в необходимом количестве поступает в организм и усваивается, но по ряду патологических причин наступает массовый распад эритроцитов (красных кровяных клеток), в результате чего концентрация железа в крови повышается. Такое состояние наблюдается при туберкулезе и гнойных инфекционных процессах.
Также возможна смешанная форма гипохромной анемии, сочетающая разные патологические процессы. Это происходит при дефиците витамина В12 и железа.
Симптомы
Симптомы анемии зависят от степени ее тяжести. Первая степень – самая легкая, человек жалуется на общее недомогание, быстро устает физически, у него снижается концентрация внимания, появляется сонливость.
Вторая степень анемии – средняя. В этой стадии к ранее описанным симптомам присоединяется одышка, головокружение, учащенное сердцебиение, кожа становится бледной.
На третьей, тяжелой стадии анемии наблюдается онемение конечностей, ногти и волосы истончаются, нарушается вкус и обоняние. При отсутствии лечения анемия тяжелой степени может привести к смерти.
У детей симптомы гипохромной анемии выражены меньше. Кроме того, малыши не всегда могут описать свои ощущения, поэтому анемия у них диагностируется по результатам лабораторных анализов. Родителям необходимо обратиться к врачу, если у ребенка бледные кожные покровы и трещинки в уголках рта, плохой аппетит и сон, вялость, если он часто простужается, отстает в физическом и психомоторном развитии.
Диагностика
При диагностике гипохромной анемии играют роль два показателя – уровень гемоглобина, который у здоровых взрослых людей составляет примерно 120–160 г/л, и цветовой показатель крови, норма которого – 0,85–1,15. Гипохромия диагностируется, когда цветовой показатель эритроцитов опускается ниже 0,8.
При анемии первой степени цветовой показатель не превышает 0,8, а уровень гемоглобина обычно выше 90 г/л. При анемии второй степени цветовой показатель ниже 0,8, а гемоглобин держится в диапазоне 70–90 г/л. При третьей степени анемии цветовой показатель ниже 0,8, гемоглобин – ниже 70 г/л.
Основной диагностический признак гипохромной анемии – гипохромия эритроцитов. У этого явления есть три степени выраженности. При гипохромии первой степени площадь поверхности эритроцита увеличивается по сравнению со здоровыми клетками, в центре появляется зона просветления. При гипохромии второй степени окрашенной в розовый цвет остается только периферическая часть клетки. При третьей степени окрашена только мембрана эритроцита, из-за чего он выглядит бледным с красным кольцом по краям.
В зависимости от типа гипохромной анемии будут отмечены и другие изменения в общем анализе крови. При железодефицитной анемии уровень сывороточного железа будет понижен, при железонасыщенной и железораспределительной – в норме.
Лечение
Лечение гипохромной анемии назначают только после определения формы заболевания и устранения его причин. Если анемия вызвана кровотечением, то его нужно ликвидировать. Если дефицит железа образовался в связи с неполноценным питанием, то лечение обязательно включает продукты, богатые белком и железом. Если анемия вызвана инфекционным или воспалительным заболеванием, то в первую очередь лечат основной недуг.
Симптоматическое лечение железодефицитной анемии включает прием железосодержащих препаратов до нормализации уровня гемоглобина, то есть примерно в течение 4–8 недель. Основные препараты на отечественном рынке – Феррум Лек, Гемофер, Фенюльс, Сорбифер дурулес, Феррофольгамма, Тардиферрон, Ферретаб. В условиях стационара, когда необходимо исключить аллергические проявления или при острых кровопотерях и заболеваниях ЖКТ, препараты железа могут быть назначены в виде инъекций. Инъекции показаны при тяжелой форме анемии. В крайних случаях возможно переливание эритроцитарной массы.
При недостатке витамина В12 назначаются инъекции Цианокобаламина на срок 1–2 месяца. При железонасыщенной анемии показан витамин В6. Сроки приема определяет врач.
Диета при лечении гипохромной анемии включает ежедневный прием 130–150 г белков (предпочтительно красного мяса). Это строительный элемент для организма, который способствует выработке гемоглобина и эритроцитов. Стоит употреблять ежедневно 100 г печени, а также рыбные, мясные или грибные бульоны, яйца, творог. Из народных рецептов в рацион полезно включать отвар шиповника, смеси сухофруктов (измельченная курага, чернослив, изюм, инжир, шиповник в равных пропорциях, подслащенные медом) по 1 ст. л. 3–4 раза в день. Показан отвар крапивы, 100–150 г тертой моркови со сметаной, вареная тыква.
Механизмы развития
В основе становления расстройства лежат три основных пути. Они могут встречаться в системе, что существенно осложняет дело и требует более тщательного терапевтического подхода.
Недостаточное поступление железа в организм
Обычно это связано с алиментарным моментом. Пациент банально недополучает элемента с пищей. Скорее всего, речь идет о сознательном выборе. Страдают от подобной проблемы пациенты на жесткой диете.
Однако возможны и не столь очевидные факторы. Например, физическая беспомощность, нахождение в условиях голода, болезнь, препятствующая нормальному потреблению пищи и прочие подобные явления.
Как правило, для коррекции достаточно стабилизировать поступление питательных веществ с едой. Изменить рацион или пройти специфическое лечение. Этот фактор считается наиболее простым в плане восстановления нормы.
Невозможность адекватного усвоения железа
В большинстве случаев проблема заключается в функциональной недостаточности органов пищеварительного тракта. В первую очередь желудка и кишечника. Именно здесь усваивается элемент.
Формально пациент может потреблять достаточное количество железа, однако суть патологии сводит все усилия по правильному питанию на нет.
Необходимо выявить нарушение и устранить его. Других способов помочь не существует. Искусственное введение препаратов извне смысла не имеет.
Проблемы распределения железа и его соединений
Третий механизм куда более опасный. Как правило, это результат опухолевого, септического процесса. Реже прочих воспалений.
Разрушаются эритроциты, потому помимо изменения цветного показателя присутствует еще и недостаток форменных клеток. Лечение требует коррекции фактора-провокатора, что может быть крайне непросто, учитывая этиологию.
В целом, гипохромия — это снижение цветного показателя (ЦП) крови до уровня 0.8 и менее. Окраска эритроцитов (красных кровяных телец) напрямую зависит от количества содержащегося в них гемоглобина.
В зависимости от интенсивности ЦП, изменений, а также прочих лабораторных показателей, врачи делают вывод о сути расстройства и его происхождении.
Информативным моментом считается равномерность окраски эритроцитов. В норме она монохромная (одноцветная), а при асимметрии говорят об анизохромии. Она чаще возникает при другой форме анемии — сидероахрестической (сидеробластной), связанной с разрушением форменных клеток.
Классификация
Подразделение патологического процесса в медицинской науке и практике разработано недостаточно.
В качестве базового критерия используется степень тяжести расстройства. В таком случае точнее вести речь о стадировании заболевания. Говорят о следующих фазах аномалии:
Легкая или первая степень
Цветовой показатель снижен незначительно, концентрация эритроцитов нормальная. Не сопровождается какими-либо симптомами.
Отклонение обнаруживается только по результатам лабораторной оценки, в большинстве случаев это случайная находка. Инцидентальная, на профилактическом осмотре.
Симптоматика может развиваться ближе ко второй стадии. Организм пока еще в силах компенсировать расстройство, когда произойдет переход на следующую фазу не известно.
Вторая, средняя степень
Умеренная гипохромия. Цветовой показатель изменяется, но не ниже 0.8, эритроциты также в норме. Клиническая картина уже есть, но пока еще симптоматика не настолько интенсивна, чтобы существенно снижать качество жизни пациента.
Лечение представляет определенные трудности, поскольку расстройство уже развитое, необходимо устранить этиологический фактор.
Без терапии прогрессирование нарушения только ускоряется. Опасности для жизни пока еще нет, но это временно.
Третья, критическая степень
Цветовой показатель существенно снижен. Обнаруживается выраженная гипохромия в общем анализе крови, симптоматика опасная, сводит работоспособность пациента к нулю, как и возможность адекватной повседневной активности.
Клиническая картина сопровождает человека постоянно. Без лечения вероятны опасные ишемические процессы, гипоксия, инвалидность или даже гибель пациента.
Степени тяжести гипохромной анемии определяются комплексом признаков, скоростью прогрессирования клиники. Все факторы рассматриваются в системе.
Указанный метод классификации активно используется при описании сути нарушения, его конкретизации.
Нередко изменение протекает параллельно с другими. Например, снижением нормальных размеров эритроцитов (в таком случае говорят о гипохромной микроцитарной анемии).
Все формы должны корректироваться как можно раньше. Поздние стадии лечатся хуже, кроме того, нет гарантий полного успеха без ущерба здоровью человека.
Симптомы
Клиническая картина, количество проявлений и их тяжесть зависит от стадии расстройства. Чем дольше существует процесс, тем больше признаков и тем они более выражены.
Примерный список выглядит следующим образом:
- Боли в мышцах, суставах, ломота в костях. Сопровождает пациента постоянно. По характеру может напоминать артрит или миозит, прочие конкретные специфические заболевания. При этом объективных данных за эти диагнозы нет, что заметно при исследовании. Интенсивность боли растет при физической активности. Сила дискомфорта увеличивается по мере прогрессирования анемии.
- Слабость, сонливость, астенические явления. Пациент не способен нормально работать, выполнять повседневные обязанности. При этом, даже обычная активность, в быту становится непосильной ношей для человека. Единственное желание — лежать, отдыхать. Возникает апатичность. В ночное время суток возможна бессонница, что является еще более мучительным состоянием. Применение специальных препаратов может решить проблему, по крайней мере, частично.
- Возможно изменение оттенка стула на более светлый. Также встречаются расстройства дефекации по типу запоров, поносов. Чередования одного и другого в короткий период времени (несколько суток). Отклонения в работе пищеварительного тракта типичны для анемий разных типов и встречаются практически всегда. В особенно запущенных случаях возможен выход билирубина в кровь и ткани, изменение оттенка кожи на желтый.
- Нарушения эмоционального фона. Больной становится раздражительным, агрессивным. Депрессивным или апатичным. Связи с какими-либо событиями нет. Вспыльчивость может провоцироваться самими незначительными явлениями. Присутствует нестабильность настроения, что проявляется резкими переменами эмоционального фона в течение считанных минут. Если не сказать секунд. Нормальное взаимодействие с пациентом затруднено.
- Шум в ушах. Сопровождает недостаточное кровообращение головного мозга. Нервные ткани, церебральные структуры недополучают кислорода, что и становится основной причиной расстройства.
- Обморочные эпизоды. Синкопальные состояния являются грозным проявлением ишемии тканей мозга. Встречаются на развитых стадиях заболевания или при изначально тяжелом течении. Необходима срочная коррекция.
- Расстройства восприятия. В первую очередь зрительного. Возникают мушки в поле видимости, фотопсии-вспышки (простейшие галлюцинации в форме ярких точек, пятен или линий). Возможно развитие скотом. Монокулярная слепота встречается, но крайне редко.
- Головная боль. Проявляется приступами по нескольку часов каждый. В течение дня эпизоды дискомфорта могут повторяться неоднократно. Расстройство характеризуется давлением, распиранием, жжением или прострелами, пульсацией в теменной, затылочной, лобной областях. Восстановление с помощью медикаментов не имеет большого смысла. Поскольку эффект краткосрочный, а то и полностью отсутствует.
- Расстройства вкусовых предпочтений. Интересным явлением на фоне анемии можно считать извращение гастрономических пристрастий. Пациент изъявляет желание потреблять несъедобные вещи. Мел, химические вещества, уголь и прочие.
- Повышенная ломкость волос, ногтей, избыточная выработка кожного сала. Встречается изменение косметических свойств тканей организма. Оно сходит на нет само после устранения основного патологического процесса.
- Одышка.
- Нарушение нормального мочеиспускания.
Верно говорить не о симптомах гипохромии, а о признаках анемии, железодефицитной или иной.
Причины
Факторов развития множество. Если говорить о самых распространенных:
- Жесткая диета. Наиболее вероятный виновник проблемы. С большой вероятностью изменения развиваются в организме строгих вегетарианцев, пациентов с нарушениями естественного процесса питания, беспомощных лиц. Восстановление предполагает изменение рациона.
- Заболевания пищеварительного тракта. В особенности кишечника и желудка. Вместе или по отдельности. От воспалительного процесса, язвенных дефектов или же рака, прочих изменений.
- Длительные незначительные кровопотери. В результате течения различных заболеваний. В том числе патологий матки и репродуктивной системы у женщин, расстройств свертываемости у больных обоих полов. Лечение требует выявления источника кровотечений и коррекции консервативным или хирургическим путем.
- Беременность. Не является аномальным состоянием. Однако ассоциируется с повышенной потребностью организма в питательных веществах. В том числе элементах, в частности железе. При недостатке наблюдаются явления анемии, разной степени тяжести.
- То же самое касается и других периодов и жизни пациента, когда необходимость в полезных соединениях растет. К таковым относятся, например, пубертатный период, детские годы, активный рост организма создает повышенную потребность во всех веществах. Такие формы анемии временные. Как только подобные моменты сходят на нет, устраняется и патологический процесс.
Причины гипохромии эритроцитов идентичны таковым при недостаточной концентрации железа, однако закономерность в обратную сторону не работает. ЖДА не всегда сопровождается изменением цветового показателя.
Диагностика
Обследование проводится под присмотром гематолога. По потребности привлекаются и иные специалисты.
Базовый стандартный перечень мероприятий включает в себя следующие процедуры:
- Оценка жалоб на первичной консультации. Врач опрашивает человека на предмет симптоматики. Клиническая картина собирается воедино, выдвигаются основные гипотезы относительно состояния.
- Сбор анамнеза. Информация, полученная в ходе этого действия крайне ценная. Поскольку проливает свет на происхождение расстройства. Важно установить все весомые факторы: вредные привычки, образ жизни, характер профессиональной и повседневной активности, перенесенные и текущие заболевания. Также прочие моменты, которые потенциально могут оказаться полезными. Методика позволяет определиться с дальнейшей тактикой диагностики.
- В обязательном порядке проводится общий анализ крови, оценке подлежат все показатели в системе. Не лишним будет пройти и биохимическое исследование.
- УЗИ органов брюшной полости дает врачам представление о состоянии структур пищеварительного тракта. Именно они зачастую выступают виновниками анемического процесса, проблем с концентрацией гемоглобина.
- В рамках того же обследования и продолжая его, оценивается кал на скрытую кровь. Положительный результат указывает на нарушения ЖКТ, сопряженные с истечением жидкой соединительной ткани.
- Полный гинекологический осмотр у женщин. Маточные проблемы могут быть незаметны на первый взгляд. Диагностика у профильного специалиста предоставляет больше информации о характере нарушения или исключает эту этиологию.
В рамках беременности и подросткового периода источник проблемы в основном очевиден. Но диагностика все равно проводится, чтобы не упустить заболевания, маскирующиеся под нормальные физиологические процессы.
Обследование может потребовать не одной итерации, вопрос решается по ситуации. В зависимости от клинического случая.
Лечение
Терапия проводится под контролем гематолога. Медикаментозными методами. Тактика зависит от того, какая форма анемии имеет место. Как было сказано, указание на ее «гипохромность» скорее описательное, обобщающее. На практике же специалисты имеют дело с двумя различными типами.
Железодефицитная анемия предполагает применение ферросодержащих препаратов. С названным элементом в составе.
В зависимости от тяжести расстройства, дозы могут быть ударными или умеренными. Длительность терапии зависит от конкретного клинического случая. В среднем коррекция занимает от 3 до месяцев. Плюс-минус.
Параллельно назначается специфическая диета с высоким содержанием железа. Естественно, если оно нормально усваивается. Пациент должен потреблять достаточное количество красного мяса. Рацион лучше обсудить с врачом.
В обязательном порядке устраняется первопричина. Основное заболевание, которое и стало виновником проблемы. Без подобного подхода никакого смысла в воздействии нет.
Если гипохромные эритроциты повышены, это значит, что имеет место иная форма патологического процесса — сидероахрестическая анемия (железонасыщенная). Справедливо отметить, что при определенных условиях количество клеток может и снижаться.
Для расстройства типичен распад красных кровяных телец и снижение нормальной циркуляции гемоглобина в этой связи.
Применение препаратов железа в этом случае строго противопоказано — станет только хуже.
Используют средства группы B6 по четко выверенной схеме. И также не забывают о коррекции первопричины.
Терапия гипохромной анемии представляет определенные сложности. Проводится под строгим контролем со стороны гематолога. По необходимости схему коррекции пересматривают.
Прогноз
В основном — благоприятный. Но все зависит от сроков начала лечения. Проще взять проблему под контроль в первые моменты.
Последствия
Ишемические процессы в головном мозге, тканях сердца и прочих, также гипоксия, инвалидность или гибель от осложнений.
Профилактика
Методы превенции не представляют большой трудности. Среди рекомендаций:
- Своевременное выявление всех болезней. В том числе пищеварительного тракта, гинекологического профиля и иных. Их коррекция.
- Отказ от курения.
- Исключение спиртного.
- Качественное питание. Рацион должен включать в себя достаточное количество животного белка, мяса.
При вегетарианском меню имеет смысл временно переключиться на иную парадигму, поскольку упрямство и принципиальность в такой момент могут негативно сказаться на здоровье.
- Полноценный отдых.
- Контроль картины крови раз в полгода. В рамках профилактических осмотров.
- Достаточный уровень физической активности. Чтобы не провоцировать застойных явлений в организме.
Гипохромная анемия — собирательное название группы расстройств. Они подлежат срочной коррекции, поскольку могут быть опасны, особенно без своевременной терапии. Вопрос выбора тактики относится к сфере ведения гематолога.
Источник: CardioGid.com
Для начала разберем вопрос, что это такое и в чем выражается гипохромная анемия. Болезнь касается состава крови и влияет на обогащение клеток организма кислородом. Именно поэтому важно вовремя заметить тревожные симптомы и определить причину нарушений.
Суть гипохромной анемии заключается в снижении концентрации гемоглобина в крови. В итоге эритроциты переносят меньшее количество кислорода. При микроскопическом исследовании заметны изменения в пигментации красных кровяных телец и их общем внешнем виде. Эритроциты становятся похожи на кольца с темным контуром. Просвет ближе к центру свидетельствует об острой нехватке гемоглобина.
Ранее мы уже писали о симптомах серповидноклеточной анемии и рекомендовали добавить эту статью в закладки.
Важно: с уровнем гемоглобина напрямую связано количество железа, которое поступает и усваивается в организме.
Можно выделить такие причины развития гипохромной анемии:
- несбалансированное питание;
- нарушение процессов усвоения железа;
- проблемы с ЖКТ;
- незначительные, но частые кровотечения, в том числе внутренние;
- значительная потеря крови в результате травмы или операции;
- инфекционные заболевания;
- отравление токсическими веществами.
В некоторых случаях анемию могут спровоцировать определенные медикаментозные препараты.
Заболевание может долгое время протекать незаметно. Часто человек замечает недомогание и слабость, но сводит это к переутомлению на работе и т.д. Насторожиться нужно в том случае, если становятся очевидными следующие симптомы:
- слабость;
- бледность кожных покровов;
- раздражительность;
- снижение умственной активности;
- сонливость;
- чувствительность к яркому свету;
- появление мушек перед глазами;
- головокружение;
- одышка;
- ускорение пульса без видимой на то причины.
Изучите также по теме лечение в 12 дефицитной анемии в дополнение к текущему материалу.
Поможет точно указать на диагноз гипохромная анемия анализ крови. В зависимости от типа болезни выделяют отклонения от нормы по отдельным показателям: уровень гемоглобина, сывороточного железа и т.д.
| Показатель | Железо- дефицитная анемия | Талассемия | Анемии при хронических заболеваниях | Сидеробластная анемия |
| Уровень железа в сыворотке крови | ↓ | N | ↓ | ↑ |
| Общая железосвязывающая способность | ↑ | N | ↓ | N |
| Уровень ферритина в сыворотке крови | ↓ | N | ↑ | Т |
| Протопорфирин эритроцитов | ↑ | N | ↑ | ↑ или N |
| Гемоглобин А, | ↓ | ↑ | N | ↓ |
Таблица: Сравнение показателей анализа крови при разных видах анемии
Различают несколько видов гипохромной анемии:
- Железодефицитная. Характеризуется общим снижением показателей, связанных с содержанием железа в организме. Это наиболее распространенный диагноз среди заболеваний этой группы.
- Железонасыщенная. При сидероахрестической анемии уровень содержания железа находится в пределах нормы, формируются его запасы в организме, но оно практически не усваивается и не участвует в построении гемоглобина.
- Железоперераспределительная. Уровень железа также находится в норме, но это связано с увеличением его количества в результате распада эритроцитов.
Реже определяется болезнь смешанного типа. Также может быть диагностирована микроцитарная гипохромная анемия. Такой тип патологии связан с уменьшением размеров клеток крови при сохранении их нормального количества.
Для уточнения диагноза следует провести общий анализ крови и при необходимости ряд других исследований. После выяснения вида гипохромной анемии устанавливается курс лечения. Так, при дефиците железа улучшить состояние больного можно с помощью специальных диет и железосодержащих препаратов, в то время как при сидероахрастической и железоперераспределительной формах такие меры не дадут никакого результата.
Лечение анемии во многом связано с причиной ее возникновения.
Важно! Основные усилия необходимо направить именно на устранение первопричинного фактора. То есть меры могут ограничиться коррекцией рациона или быть доведены до срочной операции для устранения внутренних кровотечений.
Различают такие подходы в лечении гипохромной анемии:
- остановка кровотечения и воспалительных процессов;
- нормализация состояния органов пищеварительного тракта;
- ликвидация интоксикации;
- лечение основного заболевания;
- введение в рацион пациента продуктов, богатых железом и витаминами группы В;
- прием лекарственных препаратов, компенсирующих дефицит железа.
Железосодержащие препараты применяются в виде таблеток и капсул, внутривенных инъекций. В тяжелых случаях требуется переливание эритроцитарной массы. При нормальных показателях содержания железа акцент делается на витаминной терапии с упором на витамины В6 и В12.
Мы рекомендуем изучить статью на похожую тему: Лечение апластической анемии в рамках данного материала.
Совет: при гипохромной анемии сочетайте диету и прием витаминных добавок, чтобы скорее создать депо железа в организме.
Грамотная терапия и раннее начало лечения позволят быстро решить проблему.
Причины ЖДА
Наиболее частые причины железодефицитной анемии:
- Недостаток поступления железа с пищей (когда в рационе мало продуктов, богатых легкоусваиваемым железом)
- Нарушение всасываемости железа в кишечнике (из-за различных заболеваний желудочно-кишечного тракта даже достаточное количество поступающего с пищей железа просто не всасывается).
Группы риска по развитию железодефицитной анемии:
- беременные, кормящие, женщины с длительными и обильными меструациями;
- веганы, вегетарианцы и другие люди, кто употребляет мало легкоусваиваемого железа (из мяса, рыбы железо усваивается гораздо лучше, чем из богатых железом продуктов растительного происхождения);
- люди с хроническими заболеваниями желудочно-кишечного тракта (колит, целиакия, язвенная болезнь желудка и двенадцатиперсной кишки);
- дети, которые пьют в день более 500-750 мл коровьего молока в день (оно содержит мало железа, а также ухудшает всасываемость железа в кишечнике);
- опухоли желудка, кишечника, пищевода;
- гораздо реже ЖДА может встречаться при интенсивных физических нагрузках, частых носовых кровотечениях или каких-то нечасто встречающихся заболеваниях.
Симптомы
- слабость
- утомляемость
- сонливость
- снижение работоспособности
- бледность или желтушность кожных покровов
- учащенное сердцебиение и пульс
- одышка, возникающая при физической нагрузке
- сухость и ломкость волос и ногтей
- сухость кожи
- странные пищевые пристрастия (например, некоторые пациенты едят мел).
Диагностика
Для выявления ЖДА используется определение уровня гемоглобина, эритроцитов в общем анализе крови, ферритина, сывороточного железа, общей железосвязывающей способности сыворотки (ОЖСС), среднего объема эритроцитов, трансферрина и некоторые другие.
Но в большинстве случаев достаточно сдать общий анализ крови и ферритин.
Кроме того врач может назначить другие анализы (например, достаточно часто назначается тест на наличие крови в стуле) и обследования (например эдоскопическое исследование желудочно-кишечного тракта) для определения причин анемии, а также тесты на другие типы анемий (В12-дефицитная анемия, фолиево-дефицитная анемия и др.).
Лечение
Диета:
- мясо (свинина, говядина, баранина, субпродукты — печень, сердце и др.)
- рыба
- морепродукты
- растительные продукты: капуста, брокколи, салат, бобовые, а также обогащенные железом крупы.
Но при наличии уже развившейся ЖДА не удастся скорректировать недостаток железа только диетой. Нужны препараты железа, чаще всего достаточно пероральных (употребляются внутрь, могут быть в виде таблеток, жидкости, капель), лучше использовать препараты соли железа (цитрат, фумарат, сульфат), чем полимальтозного комплекса (хуже всасываются).
Нет никакой доказательной базы, что какой-либо тип соли железа, а также лекарственная форма обладает преимуществом перед другими.
При тяжелой анемии, в ситуациях, когда надо достаточно быстро поднять гемоглобин, у тяжелых пациентов, при выраженном нарушении всасываемости железа вследствие повреждения желудочно-кишечного тракта могут быть назначены врачом внутривенные препараты железа.
Не стоит вводить препараты железа внутримышечно, это больно, малоэффективно, и чревато осложнениями в местах введения.